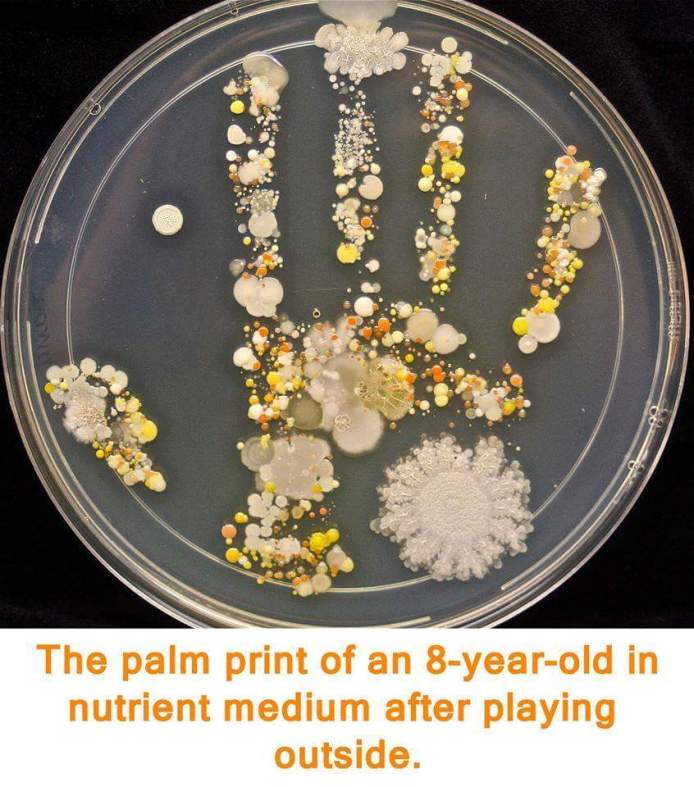

ΦΡΟΝΤΙΣΤΗΡΙ ΕΓΓΡΑΦΕΣ

follow on facebook
που θα μας βρεις
εικονες
Search
Στατιστικά
- 595.785 επισκέψεις
Κατηγορίες
Ετικέτες
2015 Evolution panelladikes panellinies Sxoliasmos thematwn Έρευνα Βιολογία Βιολογία Γενικής Βιολογία Κατεύθυνσης Βιολογία Προσανατολισμού Γ΄Λυκείου Δαρβίνος Εξέλιξη Εξεταστέα Ύλη Κεφάλαιο 1ο Γενικής Πανελλήνιες Πανελλαδικές Προτεινόμενα Θέματα Γενικής Προτεινόμενα Θέματα Κατεύθυνσης Προτεινόμενα Θέματα Χημείας Κατεύθυνσης Σχολιασμός Πανελληνίων Κατεύθυνσης Σχολιασμός θεμάτων Χημεία Γενικής Χημεία Κατεύθυνσης Χημεία ΠροσανατολισμούΦιλικά Blogs
Σχολιάστε
Comments 0